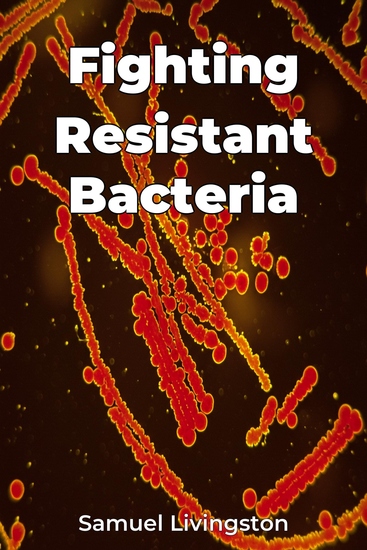

Fighting Resistant Bacteria
Samuel Livingston
Übersetzer A AI
Verlag: Publifye
Beschreibung
Fighting Resistant Bacteria addresses the urgent global challenge of antibiotic resistance, where common infections are becoming increasingly difficult to treat. The book explores the scientific basis of resistance, global efforts to control its spread, and innovative therapeutic approaches. Did you know that the overuse of antibiotics in human medicine and agriculture significantly contributes to this problem, accelerating the evolution of resistant bacteria through mechanisms like horizontal gene transfer? This book emphasizes a multi-pronged, globally coordinated approach involving surveillance, stewardship, and infection prevention. The book is structured into three parts: understanding the science of resistance, examining intervention strategies, and exploring novel solutions. It details global action plans from organizations like the WHO and CDC. What makes this book unique is its integrated perspective, combining the scientific underpinnings of resistance with practical intervention strategies and forward-looking solutions, bridging bacteriology, public health, and policy. With its clear and accessible style, this book is a valuable resource for anyone interested in understanding and combating this critical public health threat.














